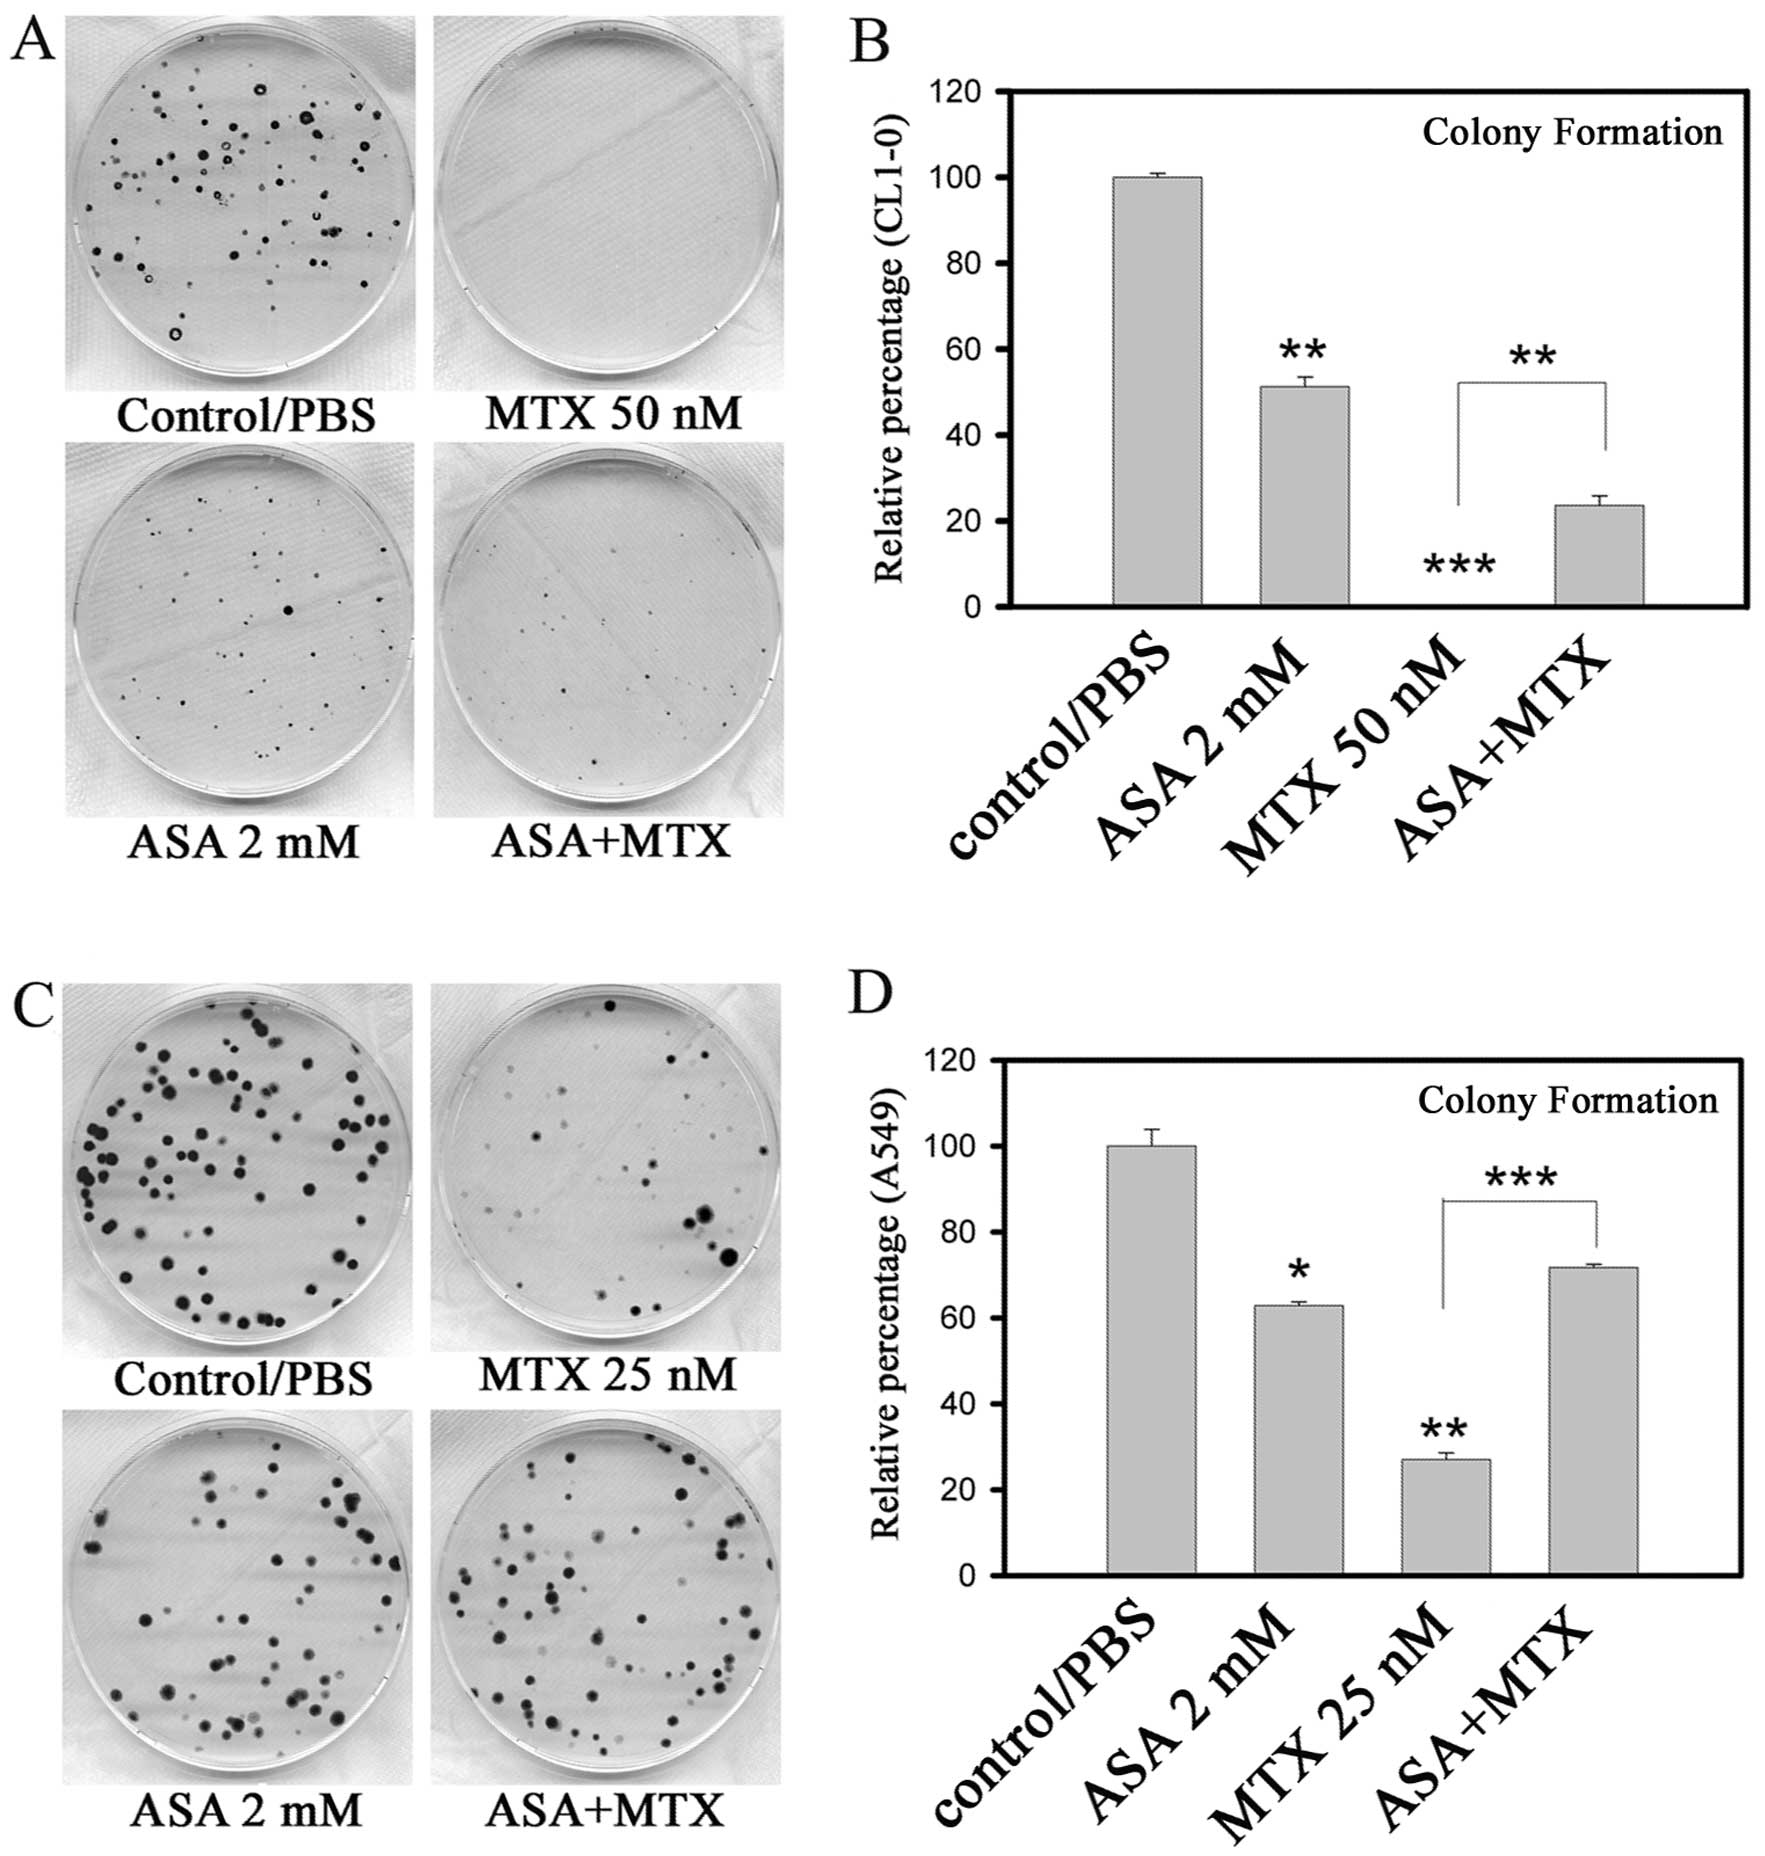

|
1
|
Fotoohi AK and Albertioni F: Mechanisms of
antifolate resistance and methotrexate efficacy in leukemia cells.
Leuk Lymphoma. 49:410–426. 2008. View Article : Google Scholar : PubMed/NCBI
|
|
2
|
Hider SL, Bruce IN and Thomson W: The
pharmacogenetics of methotrexate. Rheumatology. 46:1520–1524. 2007.
View Article : Google Scholar
|
|
3
|
Yamauchi A, Ichimiya T, Inoue K, Taguchi
Y, Matsunaga N, Koyanagi S, Fukagawa T, Aramaki H, Higuchi S and
Ohdo S: Cell-cycle-dependent pharmacology of methotrexate in HL-60.
J Pharmacol Sci. 99:335–341. 2005. View Article : Google Scholar : PubMed/NCBI
|
|
4
|
Cronstein BN: Low-dose methotrexate: a
mainstay in the treatment of rheumatoid arthritis. Pharmacol Rev.
57:163–172. 2005. View Article : Google Scholar : PubMed/NCBI
|
|
5
|
Tian H and Cronstein BN: Understanding the
mechanisms of action of methotrexate: implications for the
treatment of rheumatoid arthritis. Bull NYU Hosp Jt Dis.
65:168–173. 2007.PubMed/NCBI
|
|
6
|
Weinblatt ME, Coblyn JS, Fox DA, Fraser
PA, Holdsworth DE, Glass DN and Trentham DE: Efficacy of low-dose
methotrexate in rheumatoid arthritis. N Engl J Med. 312:818–822.
1985. View Article : Google Scholar : PubMed/NCBI
|
|
7
|
Chan ES and Cronstein BN: Molecular action
of methotrexate in inflammatory diseases. Arthritis Res. 4:266–273.
2002. View Article : Google Scholar : PubMed/NCBI
|
|
8
|
Wessels JA, van der Kooij SM, le Cessie S,
Kievit W, Barerra P, Allaart CF, Huizinga TW and Guchelaar HJ: A
clinical pharmacogenetic model to predict the efficacy of
methotrexate monotherapy in recent-onset rheumatoid arthritis.
Arthritis Rheum. 56:1765–1775. 2007. View Article : Google Scholar : PubMed/NCBI
|
|
9
|
Hani N, Casper C, Groth W, Krieg T and
Hunzelmann N: Stevens-Johnson syndrome-like exanthema secondary to
methotrexate histologically simulating acute graft-versus-host
disease. Eur J Dermatol. 10:548–550. 2000.PubMed/NCBI
|
|
10
|
Naidu MU, Ramana GV, Rani PU, Mohan IK,
Suman A and Roy P: Chemotherapy-induced and/or radiation
therapy-induced oral mucositis - complicating the treatment of
cancer. Neoplasia. 6:423–431. 2004. View Article : Google Scholar : PubMed/NCBI
|
|
11
|
Tomoda R, Seto M, Hioki Y, Sonoda J,
Matsumine A, Kusuzaki K and Uchida A: Low-dose methotrexate
inhibits lung metastasis and lengthens survival in rat
osteosarcoma. Clin Exp Metastasis. 22:559–564. 2005. View Article : Google Scholar : PubMed/NCBI
|
|
12
|
Morison WL, Momtaz K, Parrish JA and
Fitzpatrick TB: Combined methotrexate-PUVA therapy in the treatment
of psoriasis. J Am Acad Dermatol. 6:46–51. 1982. View Article : Google Scholar : PubMed/NCBI
|
|
13
|
Sweeney CJ, Takimoto CH, Latz JE, Baker
SD, Murry DJ, Krull JH, Fife K, Battiato L, Cleverly A, Chaudhary
AK, Chaudhuri T, Sandler A, Mita AC and Rowinsky EK: Two drug
interaction studies evaluating the pharmacokinetics and toxicity of
pemetrexed when coadministered with aspirin or ibuprofen in
patients with advanced cancer. Clin Cancer Res. 12:536–542. 2006.
View Article : Google Scholar : PubMed/NCBI
|
|
14
|
Pablos JL: Aspirin antiplatelet therapy
and nonsteroidal antiinflammatory drugs: comment on the 2002 update
of the American College of Rheumatology Guidelines for the
Management of Rheumatoid Arthritis. Arthritis Rheum. 46:31022002.
View Article : Google Scholar
|
|
15
|
Moysich KB, Menezes RJ, Ronsani A, Swede
H, Reid ME, Cummings KM, Falkner KL, Loewen GM and Bepler G:
Regular aspirin use and lung cancer risk. BMC Cancer. 2:312002.
View Article : Google Scholar : PubMed/NCBI
|
|
16
|
Van Dyke AL, Cote ML, Prysak G, Claeys GB,
Wenzlaff AS and Schwartz AG: Regular adult aspirin use decreases
the risk of non-small cell lung cancer among women. Cancer
Epidemiol Biomarkers Prev. 17:148–157. 2008.PubMed/NCBI
|
|
17
|
Cuzick J, Otto F, Baron JA, Brown PH, Burn
J, Greenwald P, Jankowski J, La Vecchia C, Meyskens F, Senn HJ and
Thun M: Aspirin and non-steroidal anti-inflammatory drugs for
cancer prevention: an international consensus statement. Lancet
Oncol. 10:501–507. 2009. View Article : Google Scholar : PubMed/NCBI
|
|
18
|
Kremer JM and Hamilton RA: The effects of
nonsteroidal antiinflammatory drugs on methotrexate (MTX)
pharmacokinetics: impairment of renal clearance of MTX at weekly
maintenance doses but not at 7.5 mg. J Rheumatol. 22:2072–2077.
1995.
|
|
19
|
Stewart CF, Fleming RA, Germain BF,
Seleznick MJ and Evans WE: Aspirin alters methotrexate disposition
in rheumatoid arthritis patients. Arthritis Rheum. 34:1514–1520.
1991. View Article : Google Scholar : PubMed/NCBI
|
|
20
|
Fries JF, Singh G, Lenert L and Furst DE:
Aspirin, hydroxychloroquine, and hepatic enzyme abnormalities with
methotrexate in rheumatoid arthritis. Arthritis Rheum.
33:1611–1619. 1990. View Article : Google Scholar : PubMed/NCBI
|
|
21
|
Chu YW, Yang PC, Yang SC, Shyu YC, Hendrix
MJ, Wu R and Wu CW: Selection of invasive and metastatic
subpopulations from a human lung adenocarcinoma cell line. Am J
Respir Cell Mol Biol. 17:353–360. 1997. View Article : Google Scholar : PubMed/NCBI
|
|
22
|
Keepers YP, Pizao PE, Peters GJ, van
Ark-Otte J, Winograd B and Pinedo HM: Comparison of the
sulforhodamine B protein and tetrazolium (MTT) assays for in vitro
chemosensitivity testing. Eur J Cancer. 27:897–900. 1991.
View Article : Google Scholar : PubMed/NCBI
|
|
23
|
Chou TC: Theoretical basis, experimental
design, and computerized simulation of synergism and antagonism in
drug combination studies. Pharmacol Rev. 58:621–681. 2006.
View Article : Google Scholar : PubMed/NCBI
|
|
24
|
Chou TC and Talalay P: Quantitative
analysis of dose-effect relationships: the combined effects of
multiple drugs or enzyme inhibitors. Adv Enzyme Regul. 22:27–55.
1984. View Article : Google Scholar : PubMed/NCBI
|
|
25
|
Yan KH, Yao CJ, Chang HY, Lai GM, Cheng AL
and Chuang SE: The synergistic anticancer effect of troglitazone
combined with aspirin causes cell cycle arrest and apoptosis in
human lung cancer cells. Mol Carcinog. 49:235–246. 2010.PubMed/NCBI
|
|
26
|
Rooney TW, Furst DE, Koehnke R and
Burmeister L: Aspirin is not associated with more toxicity than
other nonsteroidal antiinflammatory drugs in patients with
rheumatoid arthritis treated with methotrexate. J Rheumatol.
20:1297–1302. 1993.PubMed/NCBI
|
|
27
|
Kurth T, Hennekens CH, Buring JE and
Gaziano JM: Aspirin, NSAIDs, and COX-2 inhibitors in cardiovascular
disease: possible interactions and implications for treatment of
rheumatoid arthritis. Curr Rheumatol Rep. 6:351–356. 2004.
View Article : Google Scholar : PubMed/NCBI
|
|
28
|
Ranganathan P: An update on methotrexate
pharmacogenetics in rheumatoid arthritis. Pharmacogenomics.
9:439–451. 2008. View Article : Google Scholar : PubMed/NCBI
|
|
29
|
Krajinovic M and Moghrabi A:
Pharmacogenetics of methotrexate. Pharmacogenomics. 5:819–834.
2004. View Article : Google Scholar
|
|
30
|
Bock JM, Menon SG, Goswami PC, Sinclair
LL, Bedford NS, Domann FE and Trask DK: Relative non-steroidal
anti-inflammatory drug (NSAID) antiproliferative activity is
mediated through p21-induced G1 arrest and E2F inhibition. Mol
Carcinog. 46:857–864. 2007. View Article : Google Scholar : PubMed/NCBI
|
|
31
|
Janssen A, Maier TJ, Schiffmann S, Coste
O, Seegel M, Geisslinger G and Grösch S: Evidence of COX-2
independent induction of apoptosis and cell cycle block in human
colon carcinoma cells after S- or R-ibuprofen treatment. Eur J
Pharmacol. 540:24–33. 2006. View Article : Google Scholar : PubMed/NCBI
|
|
32
|
Resnitzky D, Hengst L and Reed SI: Cyclin
A-associated kinase activity is rate limiting for entrance into S
phase and is negatively regulated in G1 by p27Kip1. Mol Cell Biol.
15:4347–4352. 1995.PubMed/NCBI
|
|
33
|
Mateo F, Vidal-Laliena M, Canela N, Busino
L, Martinez-Balbas MA, Pagano M, Agell N and Bachs O: Degradation
of cyclin A is regulated by acetylation. Oncogene. 28:2654–2666.
2009. View Article : Google Scholar : PubMed/NCBI
|
|
34
|
Gloire G, Charlier E and Piette J:
Regulation of CD95/APO-1/Fas-induced apoptosis by protein
phosphatases. Biochem Pharmacol. 76:1451–1458. 2008. View Article : Google Scholar : PubMed/NCBI
|
|
35
|
Mollinedo F and Gajate C: Fas/CD95 death
receptor and lipid rafts: new targets for apoptosis-directed cancer
therapy. Drug Resist Updat. 9:51–73. 2006. View Article : Google Scholar : PubMed/NCBI
|
|
36
|
Kim R, Emi M, Tanabe K, Uchida Y and Toge
T: The role of Fas ligand and transforming growth factor β in tumor
progression: molecular mechanisms of immune privilege via
Fas-mediated apoptosis and potential targets for cancer therapy.
Cancer. 100:2281–2291. 2004.
|
|
37
|
O’Brien DI, Nally K, Kelly RG, O’Connor
TM, Shanahan F and O’Connell J: Targeting the Fas/Fas ligand
pathway in cancer. Expert Opin Ther Targets. 9:1031–1044. 2005.
|
|
38
|
Sowers R, Toguchida J, Qin J, Meyers PA,
Healey JH, Huvos A, Banerjee D, Bertino JR and Gorlick R: mRNA
expression levels of E2F transcription factors correlate with
dihydrofolate reductase, reduced folate carrier, and thymidylate
synthase mRNA expression in osteosarcoma. Mol Cancer Ther.
2:535–541. 2003.
|
|
39
|
Slansky JE, Li Y, Kaelin WG and Farnham
PJ: A protein synthesis-dependent increase in E2F1 mRNA correlates
with growth regulation of the dihydrofolate reductase promoter. Mol
Cell Biol. 13:1610–1618. 1993.PubMed/NCBI
|
|
40
|
Skacel N, Menon LG, Mishra PJ, Peters R,
Banerjee D, Bertino JR and Abali EE: Identification of amino acids
required for the functional up-regulation of human dihydrofolate
reductase protein in response to antifolate treatment. J Biol Chem.
280:22721–22731. 2005. View Article : Google Scholar : PubMed/NCBI
|
|
41
|
Mishra PJ, Humeniuk R, Longo-Sorbello GS,
Banerjee D and Bertino JR: A miR-24 microRNA binding-site
polymorphism in dihydrofolate reductase gene leads to methotrexate
resistance. Proc Natl Acad Sci USA. 104:13513–13518. 2007.
View Article : Google Scholar : PubMed/NCBI
|
|
42
|
Snijders AM, Hermsen MA, Baughman J,
Buffart TE, Huey B, Gajduskova P, Roydasgupta R, Tokuyasu T, Meijer
GA, Fridlyand J and Albertson DG: Acquired genomic aberrations
associated with methotrexate resistance vary with background
genomic instability. Genes Chromosomes Cancer. 47:71–83. 2008.
View Article : Google Scholar : PubMed/NCBI
|
|
43
|
Bertino JR, Göker E, Gorlick R, Li WW and
Banerjee D: Resistance mechanisms to methotrexate in tumors. Stem
Cells. 14:5–9. 1996. View Article : Google Scholar
|
|
44
|
Ercikan-Abali EA, Banerjee D, Waltham MC,
Skacel N, Scotto KW and Bertino JR: Dihydrofolate reductase protein
inhibits its own translation by binding to dihydrofolate reductase
mRNA sequences within the coding region. Biochemistry.
36:12317–12322. 1997. View Article : Google Scholar : PubMed/NCBI
|
|
45
|
Hsieh YC, Skacel NE, Bansal N, Scotto KW,
Banerjee D, Bertino JR and Abali EE: Species-specific differences
in translational regulation of dihydrofolate reductase. Mol
Pharmacol. 76:723–733. 2009. View Article : Google Scholar : PubMed/NCBI
|